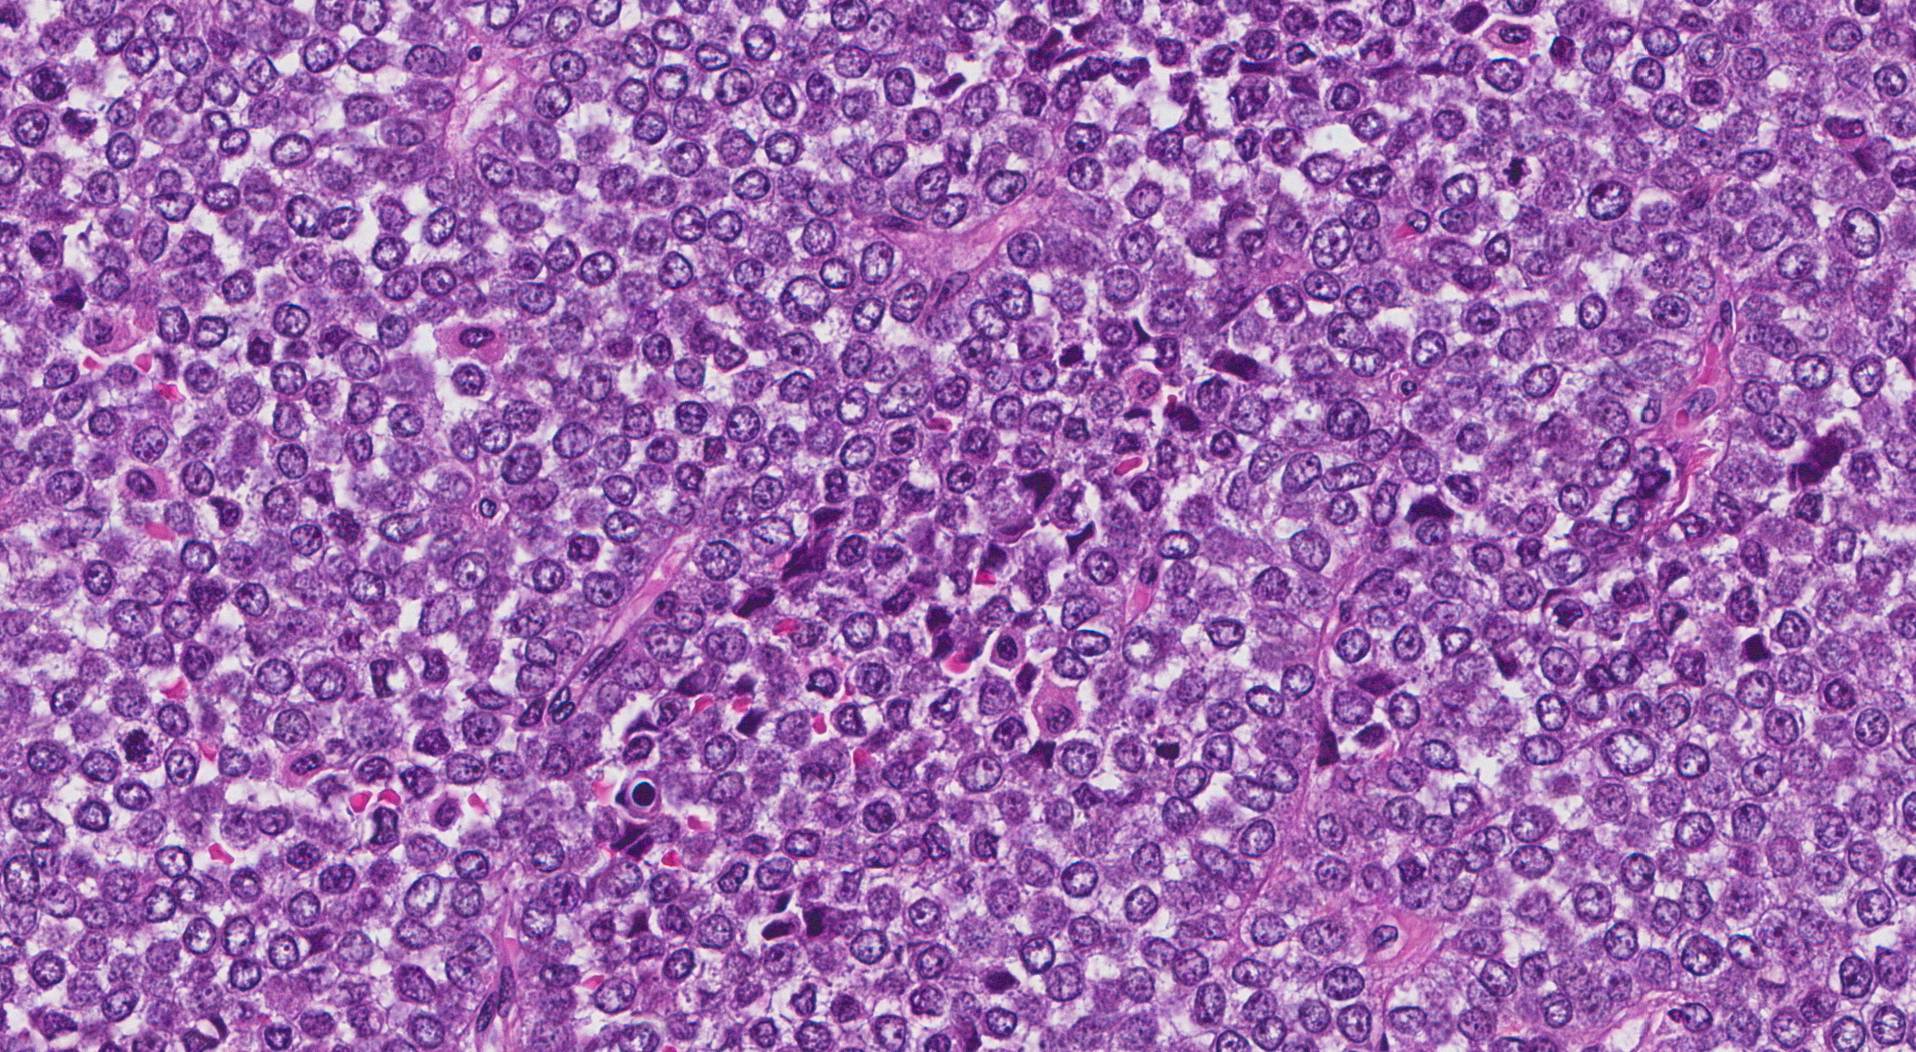
Carcinoma NUT

Diagnosticato presso l’Unità operativa complessa di Oncoematologia Pediatrica del Policlinico di Bari diretta dal dottor Nicola Santoro il primo caso pediatrico in Italia di “carcinoma NUT”. Il “carcinoma NUT” è un tumore eccezionalmente raro e a prognosi quasi invariabilmente infausta, con pochissimi casi descritti nel mondo.
Il paziente, un ragazzino di 13 anni della provincia di Bari, aveva una evidente tumefazione della parete toracica a sinistra. Dopo l’accurata caratterizzazione istologico-molecolare, cui si è giunti anche grazie alla collaborazione con la prof.ssa Rita Alaggio (direttrice del Servizio di Anatomia Patologia dell’Ospedale “Bambin Gesù” di Roma), il piccolo è stato sottoposto ad un intervento chirurgico multidisciplinare durato circa 10 ore.
Le equipe del prof. Giuseppe Marulli (Chirurgia toracica) e dei prof. Giuseppe Giudice e prof. Michele Maruccia (Chirurgia plastica), coadiuvati dall’anestesista pediatrica Giovanna Primiceri (servizio di Anestesia ospedaliera diretto da Anna Protopapa) sono riusciti nel difficile intento di asportare in maniera ampia e microscopicamente radicale la neoplasia; la parete toracica è stata quindi ricostruita con protesi in titanio ed un lembo miocutaneo microchirurgico.
Successivamente il ragazzo è stato sottoposto a trattamento radiante con tecnica Vmat, una sofisticata tecnica radioterapica, somministrato da Loredana Lapadula (servizio di Radioterapia diretto da Michele Piombino) ed ha quindi iniziato un trattamento chemio-immunoterapico intensivo. L’intero complesso programma diagnostico-terapeutico è stato coordinato da Francesco De Leonardis, medico dell’unità operativa di Oncoematologia pediatrica e condiviso con i colleghi del “Dana Farber Cancer Institute” di Boston (USA).
La collaborazione con l’istituto americano è stata preziosa nell’individuare e condividere la strategia di cura del piccolo paziente. I medici di Boston, infatti, hanno per primi identificato il rarissimo tipo di tumore circa una decina di anni fa e il “Dana Farber Cancer Institute”, un grosso e rinomato centro di ricerca e cura oncologica, possiede un registro di questo raro tumore e ha maturato esperienza nel disegnare la strategia di trattamento.
Grazie a questo considerevole impiego di risorse e professionalità oggi il piccolo ha ottime probabilità di guarire, dimostrando quale livello di eccellenza abbia oggi raggiunto il Policlinico barese nel panorama internazionale.